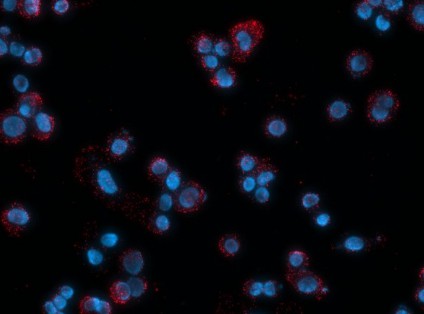

Duolink™ In Situ Red Starter Kit Mouse/Rabbit
Duolink®proximity ligation assay(PLA®) allows for endogenous detection of protein interactions, post translational modifications, and protein expression levels at the single molecule level in fixed cells and tissue samples.
Follow
the Duolink® In Situ Fluorescence Protocol to use this product. A set of short instructionsis also available.
Visit our Duolink® PLA Resource Center for information on how to run a Duolink® experiment, applications, troubleshooting, and more.
To perform a complete Duolink® PLA in situ experiment you will need two primary antibodies (PLA, IHC, ICC or IF validated) that recognize two target epitopes.This
starter kit supplies all other necessary reagents for 30 Duolink® PLA reactions, which include a pair of PLA probes (Anti-Rabbit PLUS and Anti-Mouse MINUS), red detection reagents, wash buffers, and mounting medium. Note that the primary
antibodies must come from the same species as the Duolink® PLA probes. Analysis is carried out using standard immunofluorescence assay equipment.
Specificity
The Duolink® In Situ Red Starter Kit Mouse/Rabbit
requires one primary antibody from mouse and one primary antibody from rabbit. Red fluorescence detection reagents are often used with Texas Red® filter.
Application Note
Two primary antibodies raised in different species
are needed. Test your primary antibodies (IgG-class, mono- or polyclonal) in a standard immunofluorescence (IF), immunohistochemistry (IHC) or immunocytochemistry (ICC) assay to determine the optimal fixation, blocking, and titer conditions. Duolink® PLA
in situ reagents are suitable for use on fixed cells, cytospin cells, cells grown on slide, formalin-fixed, paraffin embedded (FFPE), or tissue (fresh or frozen). No minimum number of cells is required.
Let us do the work for you, learn
more about our Custom Service Program to accelerate your Duolink® projects
View full Duolink® product list
Duolink® in situ red starter kit has been used in proximity ligation assay.[1][2]
• No overexpression or genetic manipulation required
• High specificity (fewer false positives)
• Single molecule sensitivity due to rolling circle amplification
• Relative quantification possible
• No special
equipment needed
• Quicker and simpler than FRET
• Increased accuracy compared to co-IP
• Publication-ready results
Duolink is a registered trademark of Sigma-Aldrich Co. LLC
PLA is a registered trademark of Sigma-Aldrich Co. LLC
Texas Red is a registered trademark of Life Technologies